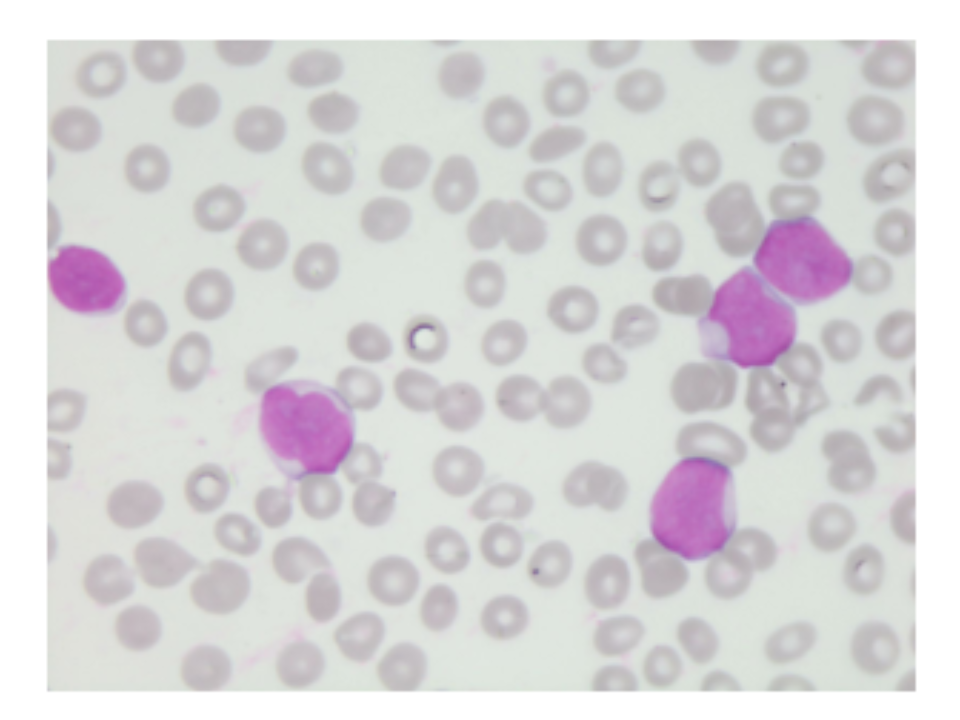
como identificar blastos

Blastos são células jovens e imaturas presentes frequentemente em extensões sanguíneas e medulares de pacientes com leucemias agudas. A citologia dos blastos é peculiar, visto que estas células possuem múltiplos nucléolos evidentes, citoplasma escasso e levemente basofílico, núcleo grande com cromatina nuclear variando entre fina e densa.
Padrão do plano de fundo
Descrição gerada automaticamente com confiança média, Imagem

Figura 1 – Blastos com cromatina fina e nucléolos evidentes em um caso de LMA. Coloração de May-Grunwald Giemsa. x1000.
Outros blastos possuem o núcleo denso ou cromatina nuclear condensada ou fechada, típicas de linfoblastos, com pouco citoplasma. Estas células são vistas no sangue periférico de pacientes com leucemia linfoblástica aguda (LLA).
Tecido visto de perto
Descrição gerada automaticamente, Imagem

Figura 2 – Blastos com cromatina condensada e esboços de nucléolos em um paciente com LLA. Coloração de May-Grunwald Giemsa. x1000.
Vale destacar que quando são encontrados blastos com bastonete de Auer, grânulos citoplasmáticos, deve-se fazer uma observação, pois estes achados são comuns em lâminas de pacientes com leucemia mieloide aguda (LMA).
Os blastos devem ser contados dentro da diferencial dos leucócitos, e toda vez que forem identificados, devem ser comunicados aos médicos, pois leucemias agudas são doenças agressivas, e que sem o devido tratamento levam o paciente a óbito.
Luiz Arthur Calheiros Leite, PhD, Especialista e Mestre em Hematologia, UNIFESP, Doutor em Bioquímica, UFPE. Professor de Pós-graduação e Coordenador em Hematologia. As imagens foram capturadas e cedidas pelo próprio autor.